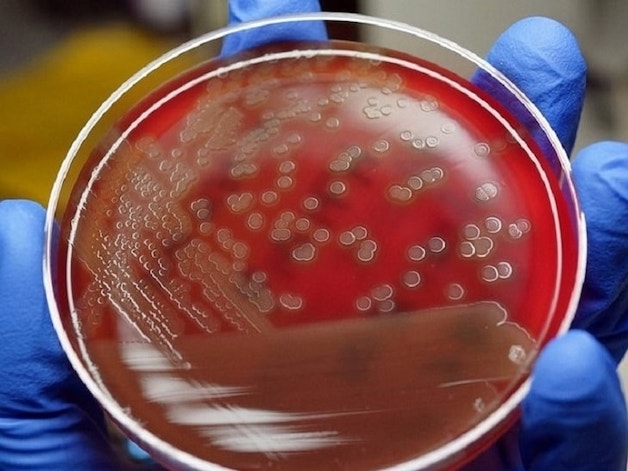

Đừng chủ quan với căn bệnh viêm khớp liên cầu
Viêm khớp liên cầu là một bệnh lý tổn thương ở xương khớp tương đối ít phổ biến. Tuy nhiên, nếu mắc phải căn bệnh này, bệnh nhân sẽ gặp nhiều khó khăn trong cuộc sống và hoạt động sinh hoạt. Do đó, bệnh cần sớm được phát hiện và điều trị kịp thời để tránh những biến chứng nguy hiểm về sau.
1. Tổng quan về bệnh viêm khớp liên cầu
Đây là một loại bệnh lý về xương khớp do vi khuẩn liên cầu (có tên khoa học là Streptococcus. sp) gây nên. Bệnh thường xuất hiện ở đối tượng bị chấn thương nặng hoặc bị nhiễm trùng khớp. Các biểu hiện bệnh diễn ra không liên tục mà được chia thành từng cơn, xuất hiện nhiều triệu chứng trên toàn cơ thể hoặc tại chỗ.
Bệnh thường xuất hiện kèm với các tình trạng nhiễm khuẩn khác như lậu cầu, tụ cầu vàng,… Tuy nhiên nếu được phát hiện sớm và điều trị theo đúng phác đồ thì người bệnh sẽ nhanh chóng khỏi. Số người mắc căn bệnh này trong cộng đồng không cao nhưng tỷ lệ bệnh nhân có tiến triển nặng dẫn tới các biến chứng phức tạp lại khá cao.
Một số biến chứng nguy hiểm có thể xảy ra với người bệnh nếu không được điều trị sớm là:
– Tác động lên sụn khớp: Gây nên tổn thương sụn khớp ở các khớp lớn. Nếu nhiều khớp sụn bị tổn thương sẽ dẫn tới tình trạng bị viêm đa khớp. Từ đó gây ảnh hưởng lớn tới sinh hoạt và sức khỏe người mắc bệnh.
– Tác động lên tim và phổi: Vi khuẩn xâm nhập sẽ gây tổn thương cho các cơ quan quan trọng của cơ thể. Do đó chức năng của các bộ phận tim, phổi sẽ bị rối loạn.
– Tác động lên những cơ quan nội tạng khác: Vi khuẩn từ các ổ viêm sẽ theo đường máu để xâm nhập vào những cơ quan trong cơ thể. Khi bị suy giảm miễn dịch, vi khuẩn gia tăng hoạt động, gây nê các bệnh lý nhiễm khuẩn và nhiễm trùng khác.

Bệnh thường xuất hiện ở đối tượng bị chấn thương nặng hoặc bị nhiễm trùng khớp
2. Nguyên nhân và triệu chứng của bệnh
2.1. Nguyên nhân gây bệnh viêm khớp liên cầu
Căn bệnh này là tình trạng nhiễm khuẩn do chủng vi khuẩn liên cầu (Streptococcus) gây nên. Sau khi các vi khuẩn này xâm nhập sâu vào cơ thể, chúng sẽ theo đường máu đi vào ổ khớp rồi dẫn tới các tổn thương và viêm nhiễm.
Thực tế, vi khuẩn liên cầu thường tồn tại ở sẵn trên da và niêm mạc của cơ thể. Trong điều kiện bình thường, chúng sẽ không gây nguy hại đối với sức khỏe. Tuy nhiên, nếu sức đề kháng của con người bị giảm, liên cầu khuẩn sẽ nhân cơ hội đó để gây hại cho con người. Khi mô mềm bị tổn thương, chúng cùng vi khuẩn khác sẽ tấn công vào các khớp. Tại đây, chúng gây ra các tổn thương và tình trạng viêm nhiễm nghiêm trọng.
Một số yếu tố tạo điều kiện cho vi khuẩn liên cầu gây nên căn bệnh viêm khớp ở người như:
– Bao khớp bị rách, tổn thương hoặc bị chấn thương khớp trong thời gian dài.
– Mắc phải các bệnh nhiễm khuẩn, nhiễm trùng khác từ liên cầu khuẩn.
– Thao tác can thiệp trực tiếp vào các ổ khớp như việc châm cứu, chọc dịch khớp, tiêm vào khớp không được tuân thủ theo quy trình hoặc làm sai kỹ thuật.
– Người có sức đề kháng yếu hoặc hệ miễn dịch bị suy giảm do có các bệnh lý khác như: bệnh lupus ban đỏ hệ thống, HIV/AIDS,….
– Biến chứng từ căn bệnh viêm phổi, viêm đa cơ do liên cầu khuẩn gây nên.
2.2. Triệu chứng điển hình của bệnh viêm khớp liên cầu
Các triệu chứng tại chỗ
– Ổ khớp bị viêm và có biểu hiện bị sưng đau, nóng đỏ một cách rõ rệt.
– Bị đau từng đợt hoặc các cơn đau kéo dài.
– Mức độ đau tăng lên nhiều khi người bệnh cử động hoặc đi lại.
– Hiện tượng tràn dịch ổ khớp viêm, mưng mủ ở những vị trí viêm.
Các triệu chứng toàn thân
– Cơ thể bị uể oải, mệt mỏi và khó chịu.
– Việc vận động gặp nhiều khó khăn, bất tiện. Cảm giác đau mỏi ngay cả lúc chỉ vận động nhẹ nhàng.
– Chán ăn, cơ thể gầy yếu và sụt cân nhanh.
– Sốt cao từ khoảng 39 – 40 độ C.
– Cảm thấy môi khô, lưỡi bẩn, miệng bị nứt nẻ, khó thở, hụt hơi.
Ngoài ra, có trường hợp bệnh nhân bị nổi hạch ở xung quanh của vùng khớp. Một số người xuất hiện các tổn thương trên da như: hăm kẽ, chốc mép, hoặc viêm quầng… Tuy nhiên đây chỉ là những triệu chứng hiếm gặp và không phổ biến.

Sốt cao cũng là một trong những biểu hiện của bệnh
3. Một số phương pháp giúp chẩn đoán bệnh
Người mắc các dấu hiệu của căn bệnh này sẽ được tiến hành chẩn đoán qua một số phương pháp sau:
3.1. Khám lâm sàng
Người bệnh được bác sĩ hỏi về tiền sử bệnh. Sau đó, bác sĩ dựa trên quan sát thông thường và kiểm tra vùng đau để bước đầu chẩn đoán bệnh.
3.2. Phương pháp xét nghiệm
Khi nghi ngờ mắc bệnh, bệnh nhân cần tiến hành các xét nghiệm. Đây chủ yếu là các xét nghiệm vi sinh để xác nhận sự có mặt của vi khuẩn liên cầu hay không. Các xét nghiệm đó bao gồm:
– Xét nghiệm máu: Giúp xác định tốc độ lắng máu, từ đó thấy được sự tiến triển của phản ứng viêm.
– Cấy máu: Là hình thức nuôi cấy vi khuẩn có trong mẫu máu của người bệnh. Xét nghiệm này giúp bác sĩ xác định chính xác chủng vi khuẩn gây nên bệnh. Qua đó đưa ra phác đồ điều trị sao cho phù hợp với bệnh nhân.
– Xét nghiệm dịch khớp: Tiến hành chọc ổ khớp để lấy dịch mang đi xét nghiệm. Dựa vào kết quả thu được để giúp bác sĩ khẳng định có hay không các mủ ở khớp.
3.3. Phương pháp chẩn đoán hình ảnh
Thông qua bước chụp X quang, chụp CT… sẽ giúp bác sĩ kết luận về vị trí và mức độ tổn thương chính xác của ổ khớp. Chẩn đoán hình ảnh sẽ giúp phân biệt được giữa viêm khớp liên cầu khuẩn với các căn bệnh khác.
Tuỳ vào tình trạng của từng bệnh nhân mà bác sĩ sẽ chỉ định phương pháp thăm khám phù hợp
Có thể nói, tuy đây là căn bệnh hiếm gặp nhưng nếu mắc phải mà không chữa trị kịp thời thì sẽ gây ra nhiều nguy hại cho sức khoẻ. Do đó, khi cơ thể có các dấu hiệu của căn bệnh trên thì bạn cần hết sức chú ý. Hãy nhanh chóng tới các trung tâm y tế có uy tín để được thăm khám và chẩn đoán chính xác bệnh.